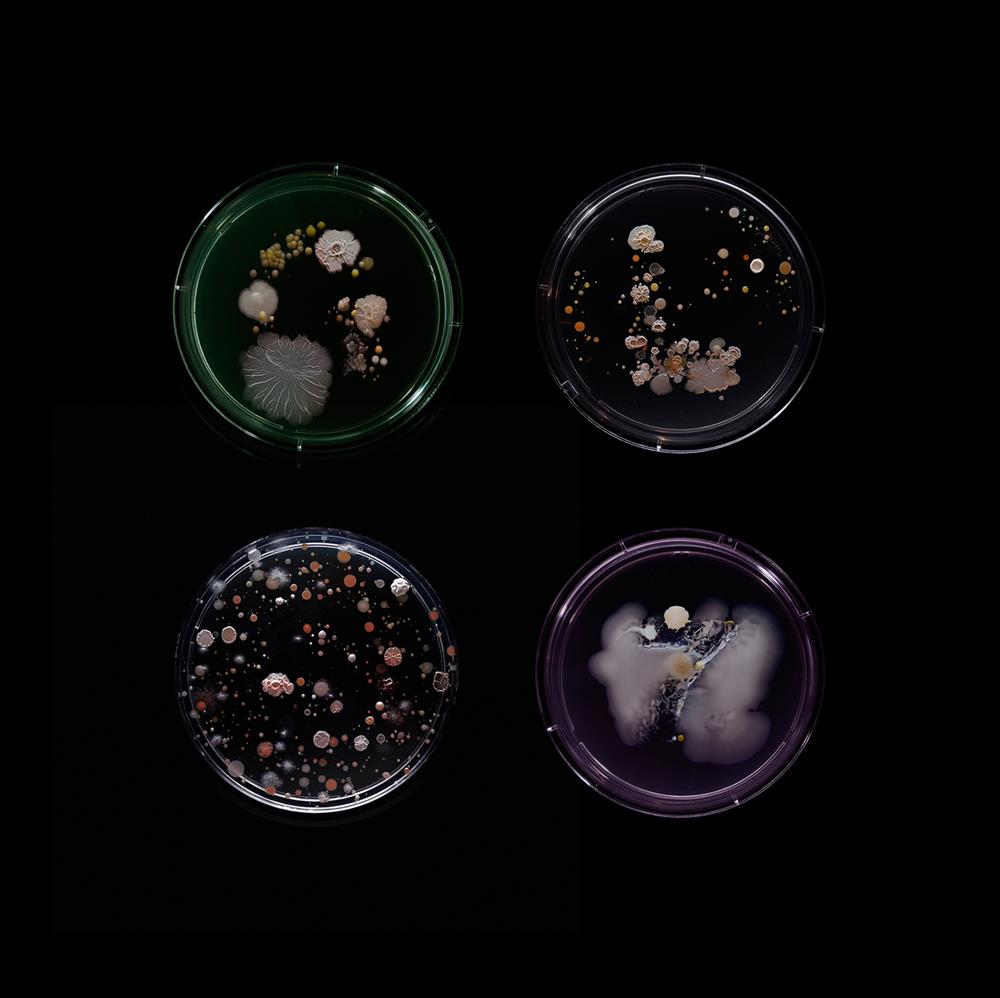
SubvisualSubway_GLS7_1500px

來自英國、深根布魯克林發展的設計師Craig Ward,在2015年的夏天突發奇想,採集了紐約地鐵中各處細菌,創作《Subvisual Subway》系列作品。以細菌為主角,或許會讓你迅速聯想到污穢、骯髒形象,但Craig Ward的表現手法,將推翻你對細菌的想像,發現從微觀的角度看事物,或許會有不一樣的驚喜。

以微觀視角建構紐約城市肖像
「如果在搭地鐵時拉了下握把,其實就間接和上百人握了手。」Craig Ward談及《Subvisual Subway》創作理念時如此說道,而他以此概念為延伸,希望能以不同視角切入,去呈現紐約的繁雜與鬧騰,以及那些肉眼難見卻潛藏於城市中的事物,構成一幅獨特的城市肖像。

紐約地鐵細菌成作品主角
創作計畫自2015年夏天展開,Craig Ward搭乘了紐約市22條地鐵路線的每班列車,利用無菌海綿從座椅、扶手、握把、窗框等處採集細菌樣本,後將其壓入注有藻膠的培養皿中,並在溫暖、黑暗的環境下靜置一週。有趣的是,Craig Ward並不知道最終成像會是如何,因此成品多彩、繽紛的樣貌,對他來說也是創作過程中的意外驚喜。
英文字母、數字有特殊意義
為讓作品回扣紐約地鐵,Craig Ward在採集時所使用的海綿,已預先割製成與地鐵路線相對應的符號,仔細端詳影像,會依稀看見英文字母或數字,那正代表著這些細菌的來歷。此舉不僅讓創作名目彰顯,也呼應了Craig Ward擅長將字型、攝影、插畫結合的創作特色。


透過這場實驗,Craig Ward以非傳統攝影手法描繪了紐約城中複雜的生態系統,背後蘊含的訊息則為無論是細菌或搭乘地鐵的人們,都是構築紐約城的一部分,即便渺小卻是貨真價實的存在。
資料、圖片|Craig Ward




































